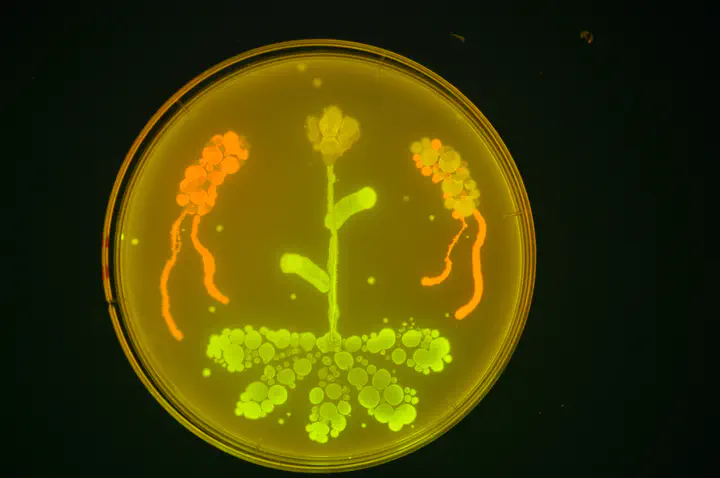

Synthetic Biology
Bacterial individuality can only be acknowledge at the single-cell level. To observe bacterial cells, we have developed a series of plasmids to tag them with unique fluorescent proteins. These plasmids are based on an expression, Tn5- and Tn7-delivery vectors. Check them out here!. If you’re interested in them, they’re also available on Addgene.org
We keep improving on our abilities to modify non-model microorganisms through new methods and tools. I’m currently working on new tools based on a CRISPR system and different transposase genes.
Also, I’m involved in the development of bioreporters that would inform us on bacterial activity and physiology in the phyllosphere at the micrometre resolution.